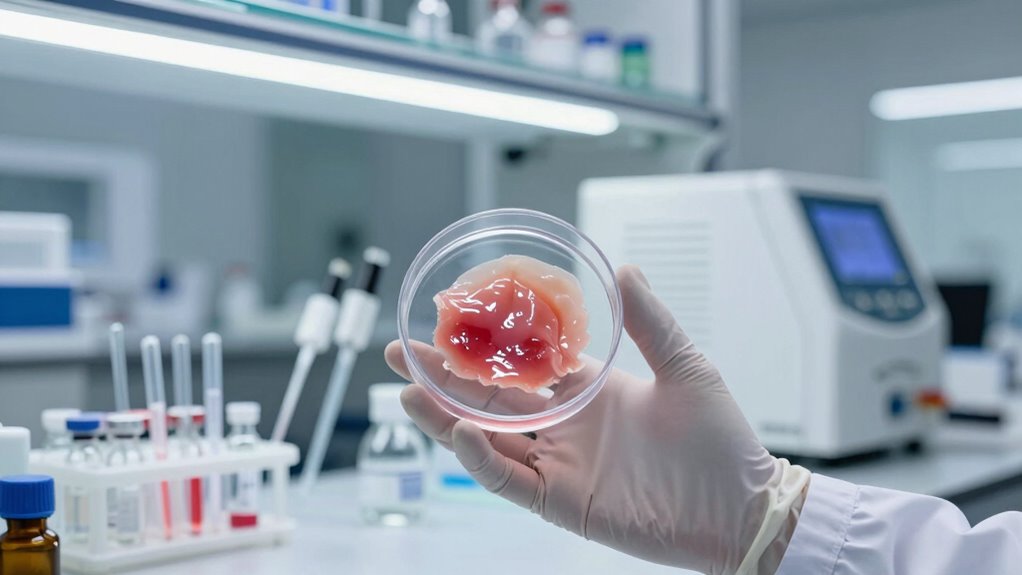
lab created sustainable skincare ingredients

Lab-grown ingredients in skincare are developed using biotechnology in labs to mimic or create natural substances, offering safer, more consistent, and sustainable options. These ingredients include synthetic botanicals, peptides, and cultured stem cells, all produced through advanced processes like chemical synthesis and cell cultivation. They’re tested for safety and effectiveness, often surpassing natural ingredients. If you’re curious about how these innovations benefit your skin and the environment, there’s plenty more to explore.
Key Takeaways
- Lab-grown ingredients are developed using biotechnology to mimic or replicate natural skincare substances outside their natural environment.
- They are produced through chemical synthesis, cell cultivation, or microbial fermentation, ensuring consistency, safety, and sustainability.
- Common lab-grown ingredients include synthetic peptides, cultured stem cells, and botanicals, offering targeted benefits and enhanced stability.
- They promote ethical, eco-friendly practices by reducing resource use, minimizing environmental impact, and supporting cruelty-free testing.
- Future trends involve personalized skincare, smart delivery systems, and AI-driven formulation, driven by biotech innovations and consumer demand.

MYOC Salicylic Acid Powder (120 g / 4.23 oz) – Cosmetic Grade Beta-Hydroxy Ingredient for DIY Skincare Formulations
Cosmetic-Grade Powder: A fine, oil-soluble beta hydroxy powder commonly used in DIY skincare formulations such as cleansers, serums,…
As an affiliate, we earn on qualifying purchases.
As an affiliate, we earn on qualifying purchases.
What Does “Lab-Grown” Mean in Skincare?
Have you ever wondered what “lab-grown” really means in skincare? Essentially, it refers to ingredients developed outside of natural environments, often using biotechnology. Instead of harvesting from plants, synthetic botanicals are created in labs to mimic natural extracts, ensuring consistency and purity. Lab-grown ingredients also include lab-created peptides, which are synthetic molecules designed to replicate natural proteins that support skin health. These ingredients undergo precise scientific processes, allowing manufacturers to produce highly targeted skincare components. This process involves advanced scientific techniques that enable the creation of specific compounds with desired properties. Biotechnology plays a crucial role in developing innovative and sustainable ingredients in modern skincare. Additionally, controlled laboratory conditions help minimize contamination and variability, leading to more reliable product outcomes. The ability to precisely control ingredient composition further enhances product effectiveness and stability. Lab-grown skincare ingredients are often more sustainable, reducing the need for harvesting wild plants or relying on natural sources. This approach guarantees higher quality, stability, and safety, giving you effective products without compromising environmental or ethical standards. Increased sustainability is one of the key advantages of lab-grown ingredients in modern skincare development.

Claranova Labs Elastin Peptides, Elastin Peptide Skin Tightening Formula, Marine Protein Complex, Daily Nutritional Support For Skin (1)
Clean Choice – Provide A Straightforward Daily Beauty Routine
As an affiliate, we earn on qualifying purchases.
As an affiliate, we earn on qualifying purchases.
How Are Lab-Grown Skincare Ingredients Made?

Ever wonder how lab-grown skincare ingredients are actually made? It all starts with synthetic synthesis, where scientists use chemical processes to create active compounds that mimic natural ingredients. These compounds are carefully designed in labs, guaranteeing consistency and purity. Synthetic processes enable precise control over the chemical structure of the ingredients. Additionally, advancements in biotechnology have enhanced the ability to produce complex molecules more efficiently. This technology ensures that the production process remains environmentally sustainable, reducing ecological impact. Modern techniques also incorporate quality control measures to ensure each batch meets strict standards for safety and effectiveness. Next, lab cultivation plays a vital role, as cells or microorganisms are grown under controlled conditions to produce specific molecules. This process allows for large-scale production without overharvesting natural resources or harming the environment. Through synthetic synthesis and lab cultivation, manufacturers can produce high-quality, sustainable ingredients that are identical to their natural counterparts. This approach significantly reduces the variability seen in naturally sourced ingredients, giving you reliable skincare products that deliver consistent results. Equity Buyers offers expertise in project management support to ensure the successful development of such innovative solutions.

STEM Natural Intelligence Anti-Aging Plant Stem Cell for Serum for Face, Hyaluronic Acid, Gluconolactone & Glycoproteins, Exosome-Inspired, Peptide-Like Skin Tightening & Firming Formula, 1oz
TARGETED HYDRATION SERUMS: Infused with a proprietary blend of peptides and polypeptides that deeply nourish and hydrate the…
As an affiliate, we earn on qualifying purchases.
As an affiliate, we earn on qualifying purchases.
What Are the Types of Lab-Grown Skincare Ingredients?

Lab-grown skincare ingredients come in several key types, each designed to target specific skin concerns effectively. Synthetic peptides are among the most common; they mimic natural proteins in your skin, promoting collagen production and reducing wrinkles. These innovative compounds allow for precise formulation and consistency, ensuring you get potent, targeted benefits. Cultured stem cells are another important type, derived from plant or human sources, and are used to stimulate skin regeneration and repair. These lab-grown ingredients enable scientists to create sustainable and ethically sourced options, minimizing environmental impact. Understanding regulatory standards for lab-grown ingredients helps ensure their safety and efficacy in skincare products. Additionally, ongoing research in biotech advancements continues to expand the potential applications of these ingredients, promising even more effective solutions in the future.

goPure NEW Instant Lift Eye Gel – For the look of Puffiness & Bags, Wrinkles, Fine Lines and Dark Circles, Anti Aging Skin Care for Men & Women with Collagen Targeting Biotech Under Eye Brightener
INSTANT VISIBLE TIGHTENING: GOPURE Instant Lift Eye Gel is powered by a proprietary Collagen Targeting Biotechnology to visibly…
As an affiliate, we earn on qualifying purchases.
As an affiliate, we earn on qualifying purchases.
Are Lab-Grown Ingredients Safe and Effective?

The safety and effectiveness of lab-grown skincare ingredients have become key considerations for consumers and industry experts alike. You can trust that these ingredients are designed to match or surpass natural alternatives in purity and consistency. To guarantee their reliability, manufacturers focus on:
- Ingredient stability — lab-grown ingredients are often more stable than natural ones, reducing the risk of degradation over time.
- Safety testing — rigorous clinical trials verify their safety for topical use.
- Controlled production — lab processes eliminate contamination risks common in natural harvesting.
This controlled environment ensures consistent quality, making lab-grown ingredients a promising option for effective skincare without the variability of natural sources. Ultimately, their safety and efficacy are backed by scientific validation, giving you confidence in their use.
How Can You Spot Authentic Lab-Gown Skincare Products?

To guarantee you’re purchasing genuine lab-grown skincare products, start by carefully examining the packaging and labeling. Look for clear indicators of marking authenticity, such as holographic seals, QR codes, or tamper-evident features. These elements help confirm the product’s legitimacy. Verify labels thoroughly—check for detailed ingredient lists, batch numbers, and expiration dates. Authentic lab-grown products often include certifications or seals from trusted organizations, so verify those as well. Be cautious of vague or inconsistent labeling, which can be a red flag. Reputable brands are transparent about their processes and provide verifiable information. By paying close attention to these details, you can confidently distinguish authentic lab-grown skincare from counterfeit or fake products, ensuring you get the quality and safety you expect. Additionally, content quality and authority play a crucial role in verifying product legitimacy, as reputable brands prioritize transparency and detailed information to establish trust with consumers. Being aware of eco-friendly practices and industry standards can also help you identify trustworthy products aligned with sustainable values. Incorporating industry certifications into your evaluation process further strengthens your ability to discern authentic products from imitations. Furthermore, understanding the regulatory environment governing skincare products can provide extra assurance of safety and authenticity. Staying informed about testing procedures and standards is essential for consumers seeking to verify the safety and authenticity of lab-grown skincare items.
What Are the Benefits of Lab-Grown Ingredients?

Have you ever wondered why lab-grown ingredients are gaining popularity in skincare? These ingredients offer several key benefits. First, they provide natural alternatives that can match or surpass their plant-based counterparts in effectiveness. Second, lab cultivation guarantees ingredient purity, reducing the risk of contamination and impurities. Third, these ingredients are more sustainable, as they require fewer resources and less land than traditional harvesting. Sustainable practices in lab cultivation also help conserve biodiversity and reduce ecological footprints. Additionally, the controlled environmental conditions in labs help minimize exposure to environmental contaminants, further increasing the safety and reliability of these ingredients. The precision of laboratory processes further ensures that each batch maintains consistent quality and potency. Moreover, the use of advanced biotechnological techniques enhances the ability to produce ingredients with specific desired properties. By using lab-grown options, you get consistent quality and potency without compromising on safety. This precision allows you to enjoy skincare products with reliable, high-quality ingredients that prioritize both safety and sustainability. Overall, lab-grown ingredients deliver a compelling combination of natural efficacy and enhanced purity, making them an increasingly attractive choice for skincare enthusiasts.
Are Lab-Grown Ingredients Environmentally and Ethically Better?

Lab-grown ingredients often have a smaller environmental footprint than traditional harvesting methods, making them a more sustainable choice. They also support ethical sourcing by reducing harm to wildlife and ecosystems. Plus, their lower carbon footprint helps lessen your skincare routine’s impact on climate change.
Reduced Environmental Impact
When considering the environmental impact of skincare ingredients, lab-grown options often promise a more sustainable alternative to traditional harvesting. They typically require less land, water, and energy, reducing their ecological footprint. Additionally, biotech companies focus on eco-friendly manufacturing processes, minimizing harmful waste and emissions. This shift supports more sustainable packaging, as products are designed to use fewer resources and generate less waste. By choosing lab-grown ingredients, you help promote a cleaner environment through reduced resource consumption. Here are three key benefits:
- Less land and water use compared to traditional farming.
- Reduced greenhouse gas emissions during production.
- Enhanced ability to implement sustainable packaging solutions.
These factors make lab-grown ingredients a smarter choice for eco-conscious skincare.
Ethical Ingredient Sourcing
Building on the environmental benefits of biotech ingredients, ethical sourcing guarantees that these innovations also promote fairness and responsibility. When lab-grown ingredients are ethically sourced, companies often prioritize cruelty-free testing, ensuring no animal suffering. This approach aligns with a commitment to kindness and sustainability. Additionally, many biotech brands adopt sustainable packaging, reducing waste and environmental impact. By choosing lab-grown ingredients, you support brands that emphasize transparency, fairness, and eco-conscious practices. This means the ingredients are produced responsibly, without overharvesting or damaging ecosystems. Ethical ingredient sourcing reflects a broader effort to make skincare more sustainable and humane, giving you confidence that your products are both effective and aligned with your values. It’s a meaningful step toward more responsible beauty choices.
Lower Carbon Footprint
Because they are produced in controlled environments, lab-grown ingredients typically require less energy and emit fewer greenhouse gases than traditional farming methods. This results in a particularly lower carbon footprint, making biotech skincare more eco-friendly. Additionally, lab-grown ingredients often utilize sustainable packaging, reducing waste and environmental impact. Transparency in ingredient sourcing allows you to see exactly what’s in your products, ensuring no hidden environmental costs. To deepen your understanding, consider these points:
- Lab cultivation minimizes deforestation and habitat destruction.
- Precise control of growth conditions reduces resource waste.
- Transparent labeling promotes responsible consumer choices.
How Much Do Lab-Grown Skincare Products Cost?

Ever wondered how much lab-grown skincare products typically cost? The pricing strategies for these innovative products vary, often reflecting their advanced biotechnology and research investments. You’ll find prices range from mid-tier to premium, depending on formulation complexity and brand positioning. While some brands may charge more due to unique ingredients or ethical sourcing, others aim to make biotech skincare accessible. As a consumer, understanding these costs helps with proper budgeting, ensuring you get quality without overspending. Keep in mind that lab-grown skincare often comes with a premium, but the benefits—like sustainability and scientifically proven ingredients—may justify the price. Comparing brands and considering your skincare needs can help you make informed choices aligned with your budget.
What Are the Future Trends in Lab-Grown Skincare?

The future of lab-grown skincare is poised for rapid innovation, driven by advancements in biotechnology and a growing demand for sustainable, ethically sourced products. You’ll see more personalized formulations tailored to your skin’s unique needs, offering targeted results. Additionally, innovative delivery systems will enhance how active ingredients penetrate your skin, making treatments more effective. Here are some key trends to watch:
- Increased customization through personalized formulations, leveraging genetic and microbiome data.
- Development of advanced, smart delivery systems that release ingredients gradually or respond to your skin’s environment.
- Integration of AI and machine learning to optimize product formulations and predict individual responses, ensuring better outcomes.
These trends aim to make lab-grown skincare more precise, sustainable, and effective for you.
Frequently Asked Questions
How Do Lab-Grown Ingredients Compare to Naturally Derived Ones?
Lab-grown ingredients often compare favorably to naturally derived ones because they’re created as synthetic alternatives, ensuring consistency and purity. While natural vs. lab-grown ingredients can differ in origin, lab-grown options are typically free from contaminants and environmental impact. You might find that lab-grown ingredients offer similar benefits, but with greater control over quality and sustainability, making them an appealing choice for clean, effective skincare.
Can Lab-Grown Ingredients Cause Allergic Reactions?
Lab-grown ingredients can cause allergic reactions, but they generally have a lower allergenic potential compared to natural counterparts. About 15-20% of people with sensitive skin react to certain ingredients, and lab-grown versions often minimize immune response triggers. However, individual sensitivities vary, so it’s wise to patch-test new products. Always check ingredient lists and consult a dermatologist if you notice irritation or allergic symptoms after using skincare with lab-grown components.
Are There Any Regulatory Standards for Lab-Grown Skincare Products?
Yes, regulatory oversight exists for lab-grown skincare products, guaranteeing they meet safety and efficacy standards. You should look for brands that prioritize quality assurance, as this indicates rigorous testing and compliance with regulations. While specific standards vary by country, reputable companies adhere to strict guidelines, giving you confidence in their lab-grown ingredients. Always check for certifications or approvals from relevant regulatory agencies to ensure you’re using safe, regulated skincare.
How Long Does It Take to Produce Lab-Grown Skincare Ingredients?
Think of the cultivation process as a delicate dance, taking around a few weeks to several months, depending on the ingredient. The production timeline varies based on the complexity of the skincare ingredient and the growth conditions. During this period, cells grow and mature, transforming into the active components you see in products. Patience is key here—this careful process guarantees the highest quality ingredients for your skincare routine.
Do Lab-Grown Ingredients Have a Shelf Life Similar to Natural Ingredients?
Lab-grown ingredients typically have a shelf life similar to natural ones, but their shelf stability depends on storage requirements. You should store these ingredients in cool, dark places and follow manufacturer guidelines to maintain potency. Proper storage helps prevent degradation, ensuring your skincare remains effective longer. Always check expiration dates and avoid exposure to heat or light, which can compromise the quality of lab-grown ingredients over time.
Conclusion
As you explore lab-grown skincare, you’ll find that these innovative ingredients are shaping a more sustainable and effective beauty routine. Coincidentally, many brands are now blending science and nature more seamlessly than ever before, making high-quality skincare more accessible. By understanding what “lab-grown” truly means, you can make smarter choices and enjoy the benefits of cutting-edge ingredients. Ultimately, embracing these advancements might just be the key to healthier skin and a healthier planet.